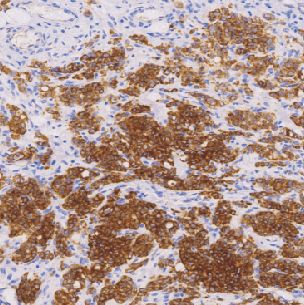
产品封面图

万千商家帮你免费找货
0 人在求购买到急需产品
- 详细信息
- 文献和实验
- 技术资料
- 形态:
Liquit
- 保存条件:
-20℃
- 克隆性:
单克隆
- 适应物种:
Human,(predicted:Mouse,Rat,)
- 保质期:
1年
- 抗原来源:
peptiede
- 目录编号:
TDCIR-0180
- 级别:
科研级
- 库存:
88
- 供应商:
武汉天德
- 宿主:
兔
- 浓度:
1mg/ml
- 抗体英文名:
Insulin-like growth factor ⅡmRNA binding protein 3(IMP3)
- 抗体名:
Insulin-like growth factor ⅡmRNA binding protein 3(IMP3)
- 规格:
1ml工作液

Insulin-like growth factor IlmRNA binding protein 3(IMP3)免抗人IMP3单克隆抗体
IMP3(胰岛素样生长因子Il mRNA结合蛋白3)是一种由580个氨基酸组成并包含4个K同源域的癌胚RNA结台蛋白。IMP3通常在早期胚胎组织内表达,但也会在起源于非小细胞肺癌和胰腺腺癌的一定比例的肿瘤性细胞中再次表达。此外,起源于膀胱、子宫颈、结肠、食管和胃等其它器官的部分癌症也已被发现可表达IMP3。该抗体可作为鉴别良性和恶性组织的一个有用标记物。
- 货号:TDCIR-0180
- 克隆号:EP286
- 阳性部位:胞质,胞膜
- 适用组织:石蜡切片
- 预处理:热修复
风险提示:丁香通仅作为第三方平台,为商家信息发布提供平台空间。用户咨询产品时请注意保护个人信息及财产安全,合理判断,谨慎选购商品,商家和用户对交易行为负责。对于医疗器械类产品,请先查证核实企业经营资质和医疗器械产品注册证情况。
文献和实验tissue,human testis tissue,human brain tissue IF:Hela,HepG2 另外有 HRP、FITC、Bintin 标记的多抗对应货号分别为: CSB-PA07179B0Rb、CSB-PA07179C0Rb、CSB-PA07179D0Rb 兔抗人淀粉样肽 beta A4 蛋白单克隆抗体 货号:CSB-MA0019501A0m 识别
一、实验原理 将抗C5a单克隆抗体包被固相聚苯乙烯板,加入经聚乙二醇(PEG)处理的待测样本,然后依次加入兔抗人C5a-IgC多克隆抗体和过氧化物酶标记的猪抗兔IsC,再加入底物2,2’-连氮-双(3-乙基苯骈唑啉-6-磺酸盐)(ABTS)和H2O2显色,于酶标仪405 mn处测定每分钟光密度增加量(OD/min),以OD/min为纵坐标,C5a标准晶浓度为横坐标绘制标准曲线图,求出待测样本中C5a的含量。 二、实验试剂 1. PBSPH7.2
蛋白质,加酶标抗抗体,保温后洗涤,加底物保温30分钟后,加酸或碱终止酶促反应,用目测或光电比色测定抗体含量。三、仪器、原料和试剂仪器聚苯乙烯96孔酶标板、微量移液管、酶联免疫阅读仪、水浴锅。原料单克隆抗体试剂1、 抗原及酶标记抗体①抗原:兔抗人IgG(Rabbit Aanti-human IgG,Code No.A0423);②酶标抗抗体:兔抗鼠IgG-HRP(Rabbit Anti-mouse IgG-HRP,Code No.P0260);均为DAKO 公司产品,使用时按照说明书要求稀释。4、 洗涤
技术资料暂无技术资料 索取技术资料